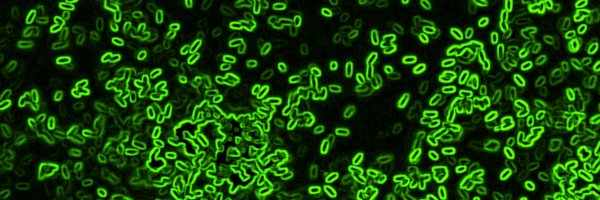
DrShawnL Profile Banner

Shawn Lewenza
@DrShawnL
Followers
986
Following
5K
Media
91
Statuses
3K
Professor of Microbiology. Open and online education, Athabasca University. Research partner, University of Calgary. 🧫🔬🥼
Joined October 2013
Hey Microbiology tweeps, can plasmids be easily lost without antibiotic selection? Ever had it happen to you? Does it depend on the plasmid? Thoughts or references appreciated!
31
19
149
I can’t believe this needs to be said. TransGENIC mice are not TransGENDER mice
3K
13K
162K
Come join us! Two tenure track positions in Environmental Molecular Biology and Community or Ecosystem Ecology in the Department of Chemistry and Biology @TorontoMetSci. Please RT https://t.co/foqhglEFAf
https://t.co/GWrdRH5l8g
0
4
2
Want to learn about polio vaccines and how great they work, with some risk, read this thread. The choice is clear.
My replies are perpetually full of anti-vaxxers these days telling me about polio vaccines. Not shockingly, most of what they are saying is wrong. Luckily, I trained with @profvrr & he taught me a few things about poliovirus. So let’s discuss the king of the Picornaviridae👇🏻
0
1
0
I will apologize for the gene edited baby experiment, only if their parents have requested it. However, they are happy with the results now.
260
479
7K
Hey microbiology gene expression folks, do you know if a Pseudomonas sigma 70 promoter will be expressed in E. coli? I've read that Pseudomonas is a good host for E. coli promoters, what about the opposite scenario?
0
0
1
Biosensors can and should be used in environmental monitoring for many reasons. Here is the publication describing our naphthenic acids detecting biosensors for oil sands and bioremediation related applications. https://t.co/bI6oUILtE5
pubs.acs.org
After extraction of bitumen from oil sands deposits, the oil sand process-affected water (OSPW) is stored in tailings ponds. Naphthenic acids (NA) in tailings ponds have been identified as the...
0
0
0
Every 6 seconds, someone dies from an antibiotic-resistant infection. Today, on day 242 of the year, over 3.2 million people have already been lost to #AMR. That's the equivalent of 85 plane crashes per day every day. Everybody should be talking about this.
0
58
92
I love it when humans push the boundaries further and further, breaking world records, going beyond what we thought was possible, living to our maximum potential. And the bittersweet reality of moving forward in so many areas, and yet still plagued by war and violence.
HISTORY MADE 💥 - Humans have untapped potential. Winning 100m freestyle by more than his body's length in an Olympic final is something out of this world. Pan Zhanle just did it. Look at how close everyone else is. Inches. 46.40 is in-human, but proves what we can achieve
1
0
1
Please RT: My team is hiring! We are looking for a talented microbiologist with experience in genetics and anaerobic culture. We seek to understand how gut bacteria can affect our brains, behaviour and happiness. Apply at link below. @UCalgary @BioSciUofc
https://t.co/LOpIIg8viI
0
47
57
What is the most amazing biological process in the human body?
4K
331
4K
I don’t think the Listerine company will like these results: daily use of Listerine leads to higher abundance of dental pathogens.
The effect of daily usage of Listerine Cool Mint mouthwash on the oropharyngeal microbiome: a substudy of the PReGo trial. Available to read in #JMedMicro: https://t.co/6MBvm25cey
0
1
10
Non-lactic acid producing S mutant in this probiotic to "cure" cavities. I'm curious what the microbiome folks think of this concept/product?
I’m about to do the Lumina treatment, a cure for dental cavities developed by Lantern Bioworks. I figured I’d do an unboxing and let you come with me on this journey. Here’s the box:
0
0
3
It was a long time coming, but our work on constructing biosensors to monitor naphthenic acids in oil sands tailings ponds is now out as preprint.
Construction of whole cell bacterial biosensors as an alternative environmental monitoring technology to detect naphthenic acids in ... https://t.co/5j5gjv7tBO
#biorxiv_micrbio
0
0
6
Biosensors using outer membrane damage-responsive promoters are useful tools for discovering antimicrobials that specifically disrupt the outer membrane. @DrShawnL
https://t.co/vcuFnpjD39
0
1
5
I'd like to know how the Viome Cancer Detection test works. Interesting that they have consent to do sequencing on 600,000 patient samples. "Viome has the world’s largest database of human and microbial gene expression from saliva, blood and stool samples"
I spent several months earlier this year investigating "precision nutrition" microbiome company Viome and its colorful founder, only for both scientists and former employees to share some shocking revelations. My latest feature: https://t.co/VZrz0X6GqR
0
0
4
Do you use the NPN uptake assay to measure OM disruption? We think this new biosensor assay is a great alternative, much easier and many other advantages. We used it here as a high throughput method to discover antimicrobials that cause OM damage.
journals.asm.org
New approaches are needed to discover novel antimicrobials, particularly antibiotics that target the Gram-negative outer membrane. By exploiting bacterial sensing and responses to outer membrane (OM)...
0
0
0